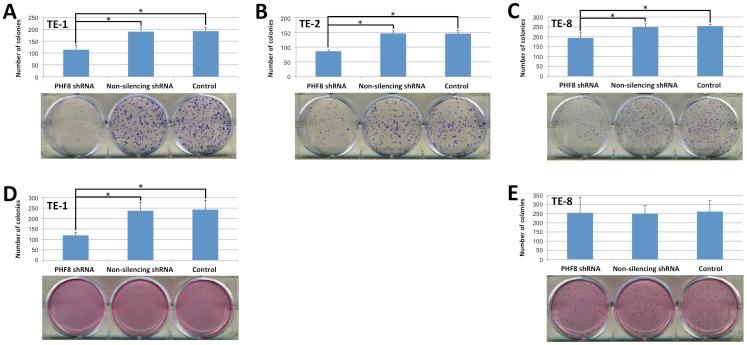
https://cdn.ncbi.nlm.nih.gov/pmc/blobs/a8b6/3795633/51678da8c1c8/pone.0077353.g002.jpg

PHF8 组蛋白去甲基酶在食管鳞状细胞癌中的致癌特征。
Oncogenic features of PHF8 histone demethylase in esophageal squamous cell carcinoma.
机构信息
Department of Medicine and Dan L. Duncan Cancer Center, Baylor College of Medicine, Houston, Texas, United States of America ; Department of Gastroenterology, Beijing Friendship Hospital Affiliated to Capital Medical University, Beijing, China.
出版信息
PLoS One. 2013 Oct 11;8(10):e77353. doi: 10.1371/journal.pone.0077353. eCollection 2013.
Esophageal cancer is the sixth leading cause of cancer-related deaths worldwide. It has been reported that histone demethylases are involved in the carcinogenesis of certain types of tumors. Here, we studied the role of one of the histone lysine demethylases, plant homeodomain finger protein 8 (PHF8), in the carcinogenesis of esophageal squamous cell carcinoma (ESCC). Using short hairpin RNA via lentiviral infection, we established stable ESCC cell lines with constitutive downregulation of PHF8 expression. Knockdown of PHF8 in ESCC cells resulted in inhibition of cell proliferation and an increase of apoptosis. Moreover, there were reductions of both anchorage-dependent and -independent colony formation. In vitro migration and invasion assays showed that knockdown of PHF8 led to a reduction in the number of migratory and invasive cells. Furthermore, downregulation of PHF8 attenuated the tumorigenicity of ESCC cells in vivo. Taken together, our study revealed the oncogenic features of PHF8 in ESCC, suggesting that PHF8 may be a potential diagnostic marker and therapeutic target for ESCC.
食管癌是全球癌症相关死亡的第六大主要原因。据报道,组蛋白去甲基酶参与某些类型肿瘤的发生。在这里,我们研究了组蛋白赖氨酸去甲基酶之一,植物同源结构域手指蛋白 8(PHF8)在食管鳞状细胞癌(ESCC)发生中的作用。通过慢病毒感染使用短发夹 RNA,我们建立了稳定的 ESCC 细胞系,其 PHF8 表达持续下调。PHF8 在 ESCC 细胞中的敲低导致细胞增殖抑制和细胞凋亡增加。此外,锚定依赖性和非依赖性集落形成均减少。体外迁移和侵袭实验表明,PHF8 的敲低导致迁移和侵袭细胞数量减少。此外,下调 PHF8 减弱了 ESCC 细胞在体内的致瘤性。总之,我们的研究揭示了 PHF8 在 ESCC 中的致癌特征,表明 PHF8 可能是 ESCC 的潜在诊断标志物和治疗靶点。